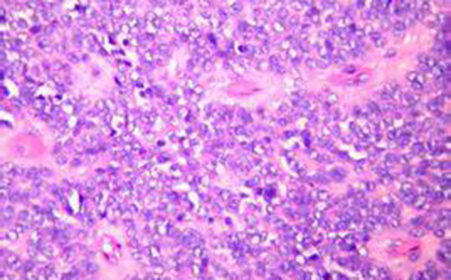
多发性肌炎有哪些典型症状 _多发性肌炎

细针吸取细胞学在增生性肌炎诊断中的价值.pd
800x1117 - 897KB - PNG

66岁老年女性右上臂肿块,增生性肌炎? [病例帖
640x480 - 32KB - JPEG

增生性肌炎
600x450 - 34KB - JPEG

增生性肌炎
600x450 - 42KB - JPEG
多发性肌炎有哪些典型症状 _多发性肌炎
451x280 - 143KB - JPEG

高手进阶:增生性肌炎的超声表现
850x649 - 45KB - JPEG

高手进阶:增生性肌炎的超声表现
850x649 - 36KB - JPEG

如何预防儿童良性肌炎|儿童急性良性肌炎|增生性肌炎
640x960 - 84KB - JPEG

如何预防儿童良性肌炎|儿童急性良性肌炎|增生性肌炎
600x600 - 110KB - JPEG

如何预防儿童良性肌炎|儿童急性良性肌炎|增生性肌炎
945x350 - 25KB - JPEG

如何预防儿童良性肌炎|儿童急性良性肌炎|增生性肌炎
280x420 - 35KB - JPEG
骨化性肌炎的临床与病理诊断
630x465 - 96KB - JPEG

如何预防儿童良性肌炎|儿童急性良性肌炎|增生性肌炎
640x960 - 115KB - JPEG

多发性肌炎重要治疗方法是什么_多发性肌炎
451x280 - 32KB - JPEG

如何预防儿童良性肌炎|儿童急性良性肌炎|增生性肌炎
280x420 - 37KB - JPEG
增生性肌炎(Proliferativemyositis,PM)是一种少见的良性炎症性肌病,以嗜碱性巨细胞和纤维母细胞增生为
增生性肌炎是一种组织形态与增生性筋膜炎相同的良性病变,但是只是病变累及的是肌肉组织的间质。
多发性肌炎 乳腺囊性增生 骨化性肌炎 增生性贫血 外伤性骨化性肌炎 增生性息肉 急性病毒性心肌炎 增生性
增生性肌炎是一种组织形态与增生性筋膜炎相同的良性病变,但增生性肌炎病变累及的是肌肉组织的间质。
增生性肌炎是一种组织形态与增生性筋膜炎相同的良性病变,但是只是病变累及的是肌肉组织的间质。主要发生于
增生性肌炎-增生性肌炎是一种组织形态与增生性筋膜炎相同的良性病变,但是只是病变累及的是肌肉组织的间质
增生性肌炎 病情描述: 男,34岁。2009年颈部胸所乳突肌肿物,无色硬压微疼,手术病理[增生性肌炎]后来复发4
健康咨询描述:医生您好,我父亲62病情分析: 好,考虑可能是由于血液循环不良引起的这种情况。指导意见: